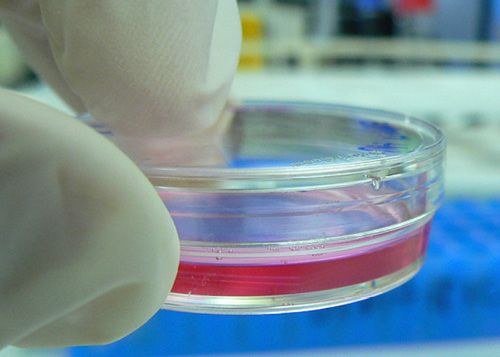

Highlight

$7.8 million funding for Aussie ideas
Assistant Minister for Innovation Wyatt Roy announced further commercialisation grants under the Entrepreneurs’ Programme.
Computer vision saves lives
A new automated detection system increases how efficiently we diagnose bacterial infections.

Which businesses are at COP21 and why?
The COP21 climate talks in Paris are not just bringing together political powers, but corporate ones too.

Winning the space race
First Australian scientist and first woman to lead project team for life on Mars, Dr Abigail Allwood, returns home to share her research and work with NASA.

Koala genome reveals its secrets
The University of Sydney and other groups have mapped the koala genome, helping to better conserve the charismatic species.

Growth factor
Curtin’s John De Laeter Centre, a suite of high-precision instruments and global collaborations are creating an innovation hub, where engineering and science researchers partner with industry.

A planet in the making
The process by which planets form and grow has been directly observed for the first time.

Annual honorific awards
Innovators and leading thinkers are recognised in the Australian Academy of Science’s annual honorific awards.

Partnering for research impact
Cooperative Research Centres are producing important results to help safeguard Australia.

Winner of the 2015 CSL Florey Medal
National honour for pioneer who found brain stem cells and is now waking them up with exercise.

Smart home design gets AccuRate
AccuRate is a smart software tool that can calculate a home’s annual energy requirements down to an hourly rate.

Australia: nation of inventors or innovators?
Karen Taylor-Brown shares ideas for an innovative future from last week’s inaugural Science Meets Business event.

Radar for driverless cars
New technology that upgrades conventional car sensors into 360-degree radar has been launched in Australia.

EMU High-Resolution Backscattering Spectrometer
EMU can help scientists to better understand human biology.

$1.5 billion in funding for university research
More than $1.5 billion will be available over four years to support Australia’s world-class university researchers.

Science beats sport at the 2015 Publish Awards
Refraction Media was announced Australia’s Best Small Publisher at the 2015 Publish Awards.

Passage of the Medical Research Future Fund Bill
The passage of the MRFF Bill 2015 will strengthen Australia’s position as a global leader in medical research.

Microtechnology manufacturing success
MiniFAB have risen to success through the production of micro-scale technologies produced for a global market.

Smart waste solutions with algae and more
MBD Energy is utilising algae and other sources of energy for smart waste solutions.

Can driverless cars save the planet?
Driverless cars could provide considerable economic and environmental benefits for Australia.

Housing industry could save auto jobs
Growth in Australia’s modular building housing industry could save jobs from the auto manufacturing industry.

Why DVDs are the new cool tech
Researchers at Swinburne University have developed an innovative approach to increasing the storage capacity of DVDs.

Irrigation innovation
Rubicon is an Australian innovation success story involved in massive irrigation projects in China.

Australia Asia innovation
A revolution in the commercialisation of science ingenuity is taking Australian ideas abroad – with a strong focus on reaching the Asian market and furthering Australia Asia innovation.
